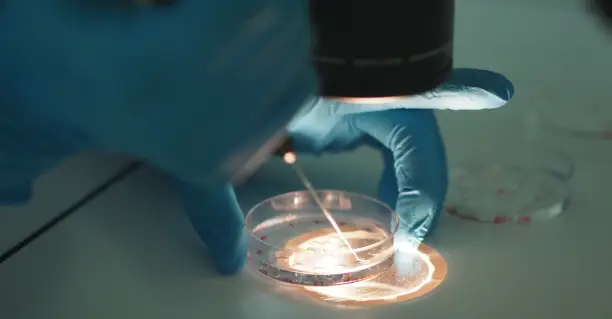
宫腔积液对试管移植的这些影响你需要了解

每位試管媽媽都希望能一次成功,而胚胎移植成功的關鍵在于:良好的子宮內膜,優質的胚胎和健康的身體狀態,有些試管媽媽在移植前,卻檢查發現了宮腔積液,這該怎么辦?會不會影響試管移植的成功率?
什么是宮腔積液?
宮腔積液是指子宮腔內積存的一定量液體,分為生理性和病理性積液。生理狀態生殖黏膜上皮分泌的液體;病理狀態的炎性分泌物、膿液和血性液體。
宮腔積液形成的原因?
一,生理性宮腔積液:
1、排卵后宮頸黏液栓阻塞宮頸口,導致宮腔分泌液蓄積。
2、輔助生殖技術助孕治療中,通常采用大劑量藥物促排卵,常常刺激子宮內膜反應性的液體分泌而產生的積液。
3、在卵巢過度刺激綜合征患者中,宮腔積液的發生率較高。
4、輸卵管積液倒流形成的積液。

二,病理性宮腔積液:
1、輸卵管病變輸卵管慢性炎癥、梗阻時常伴有輸卵管積液的產生。
2、子宮內膜炎當發生子宮內膜炎時,宮腔內的炎性滲出液蓄積而形成宮腔積液。
3、宮頸病變發育畸形、狹窄、宮頸粘連、宮頸腺癌等容易引起宮腔積液。
4、子宮疾病子宮腺肌病、子宮肌瘤、子宮瘢痕憩室等,均有可能導致宮腔積液的發生。
5、惡性病變子宮內膜結核、子宮頸癌、子宮內膜癌等惡性病變時,隨著病灶的生長、壞死,膿性分泌物不斷增多,也容易引起宮腔積液。
6、宮腔粘連宮腔粘連、重度盆腔粘連,粘連阻斷經血排出從而致宮腔積液。
宮腔積液對試管移植有影響嗎?
生理性的宮腔積液通常對ART的結局影響不大;病理性宮腔積液通常含有炎性因子,一方面對胚胎具有毒性作用,抑制胚胎發育,損傷子宮內膜容受性,另一方面對宮腔有沖刷作用,干擾胚胎著床。

宮腔積液一般怎么治療?
1、促排卵周期中hCG日前后出現的宮腔積液,可能為生理性,量不多且一過性的,不需要特殊處理,可期待觀察,胚胎移植日這些積液可能消失,可以如期胚胎移植。
2、如果宮腔積液過多,建議取消本周期的胚胎移植,行全胚冷凍保存,預防卵巢過度刺激綜合征。
3、對疑似病理性的宮腔積液,需要進一步排查原因:
①如輸卵管積水,可以進行輸卵管粘連松解+造口、輸卵管阻斷等;
②如宮頸、宮腔粘連造成的宮腔積液,需行宮腔鏡檢查,處理粘連;
③如盆腔慢性炎癥、子宮內膜炎給予抗生素治療;
④如子宮瘢痕憩室,可考慮進行憩室修補術;
⑤子宮腺肌瘤或子宮肌瘤考慮手術或藥物保守治療。
出現宮腔積液并不是都不能進行胚胎移植,要具體情況具體分析。就如最近我們有三位患者,都是冷凍胚胎移植,在準備內膜的過程中都出現了少量宮腔積液,由于這三位患者都沒有超聲下可見的輸卵管積水,無剖宮產手術病史,既往宮腔鏡檢查也沒有宮腔器質性病變,所以我們均按照冷凍胚胎移植的流程進行內膜準備、黃體轉化,在胚胎移植前一日和移植當日進行B超檢查,都沒有再發現宮腔積液,照常進行胚胎移植,三位患者均順利懷孕,如果移植當日還有較明顯宮腔積液,那么移植就要取消了。
當出現宮腔積液這種癥狀時也不必太焦慮,查明原因,遵醫囑積極治療及處理,宮腔積液大部分能得到解決的。
